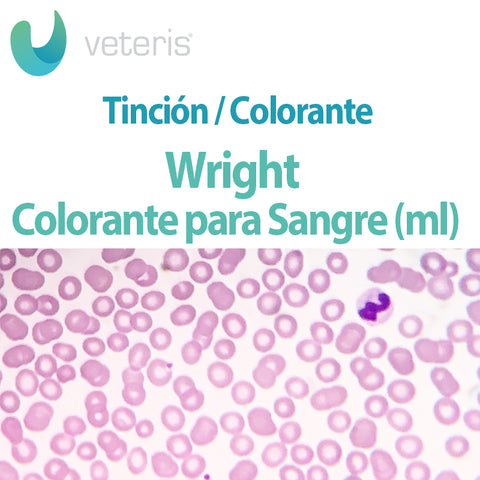

Wright Colorante para Sangre
64840-500 | Nacional
Descripción del producto
Tinción Wright en Militros
Equipo de colorantes para frotis sanguíneo, compuesto por dos soluciones:
- Wright colorante para sangre.
- Buffer de fosfato pH 6.4.
Presentaciónes: 500 ml y 1 L.
Comparte este producto
